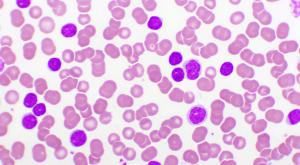
Adding Venclexta to Chemotherapy Improves Survival in Some with AML Who Are Ineligible for Standard Treatment

One patient with breast implant-associated anaplastic large cell lymphoma spoke out for herself throughout therapy — and encourages other patients do the same.

One patient with breast implant-associated anaplastic large cell lymphoma spoke out for herself throughout therapy — and encourages other patients do the same.

A retrospective study of patients with COVID-19 showed that those with cancer were not more likely to experience severe symptoms or death due to the virus than those without cancer. Rather, only age and obesity were associated with poor COVID-19 outcomes.

Paying attention to the updated nutritional labels on food can help Americans stay within dietary guidelines and prevent illness, including cancer.

One man discovered that his experience with testicular cancer inspired jokes he could share with others.

The FDA is reviewing what could become the first-ever medication specifically for kidney cancer associated with von Hippel-Lindau disease.

Three targeted drugs have recently been approved to treat diffuse large B-cell lymphoma, broadening the treatment options for patients with this aggressive blood cancer, according to Dr. Germame Ajebo.

The RACE for Children Act will create more clinical trial options for young patients with cancer and, ultimately, more pediatric oncology drugs.

One recently approved drug and two experimental treatments offer the promise of a wider range of options for patients with follicular lymphoma, according to Dr. Germame Ajebo.

Twelve works will be selected to appear in a 2021 CURE® calendar, and all submissions will be displayed in the magazine’s online art gallery.

Giving fewer courses of chemotherapy and no radiation could become a new standard for patients with stage 1 or 2 diffuse large B cell lymphoma based on the results of a recent study.

A meta-analysis of six clinical trials showed that standard treatment regimens for high-risk multiple myeloma may be more effective at delaying disease progression if they are given in combination with the targeted drug Darzalex (daratumumab).

Stephanie Walker, who was diagnosed with metastatic breast cancer in 2015, recalls how her disease has pulled the rug out from underneath her.

Susan Swanson, who was diagnosed with metastatic breast cancer in 2014, says it’s very important for patients to surround themselves with a good support network.

Kirby Lewis, who was diagnosed with breast cancer in 2012 and whose disease metastasized in 2016, says his diagnosis helped his care team detect a heart condition.

“The future is not yours,” says Pam Haldeman, who has metastatic breast cancer. “A way to get back a little bit of control is to be your own advocate and get aggressive in researching and going to every conference or retreat available.”

“Most kinds of breast cancer are potentially curable, but metastatic breast cancer is not,” says Kathleen Friel, lab director at the Burke Neurological Institute of Weill Cornell Medicine. “People assume, ‘Oh, you must be fine because you look fine.’ It puts a lot of expectations on us that, if somehow we’re strong enough, then we’ll beat this disease.”

A group extends a hand to those affected by breast or reproductive cancers, especially younger previvors, patients and caregivers.

Just one week of radiation therapy after surgery for early-stage breast cancer is as safe and effective as longer courses, researchers report.

Combining the immunotherapy Keytruda with a CAR-T cell therapy that targets the proteins CD19 and CD22 generates complete responses with minimal side effects, results from an early study demonstrate.

Adding the targeted drug Tukysa (tucatinib) to Herceptin (trastuzumab) and the chemotherapy Xeloda (capecitabine) lengthens life and time until disease progression in patients, without decreasing their health-related quality of life, researchers found in a follow-up to the HER2CLIMB study.

In a clinical trial, adding the CDK4/6 inhibitor Ibrance (palbociclib) to the hormonal treatment Faslodex (fulvestrant) delayed disease progression in postmenopausal women with hormone receptor-positive, HER2-negative advanced breast cancer.

After a recommendation against routine prostate cancer screening, rates of early disease declined while the incidence of advanced disease rose. The trend highlights the difficult balance between screening and potential overtreatment.

New treatments are needed for penile cancer, but it’s difficult to test drugs in clinical trials because the disease is so uncommon.

For some patients with metastatic kidney cancer, undergoing surgery after targeted or immune therapy sparks better health outcomes.

A growing number of treatments are available to men whose prostate cancer has spread and become resistant to hormonal therapy.

Five-year follow-up data from the phase 3 SOLO-1 trial demonstrates a nearly five-year delay in disease progression with Lynparza compared with a delay of just over a year with placebo in women with newly diagnosed, advanced ovarian cancer harboring a BRCA gene mutation.

New guidance from the Food and Drug Administration recommends that the makers of breast implants include a black-box warning, a patient decision checklist and other information on product labels that will help protect them against a cancer and an autoimmune condition that can arise from use of the devices.

A woman shares her late husband’s journey with advanced penile cancer to help others receive a diagnosis early, when the disease is still highly treatable and even curable.

After enjoying visits from therapy dogs during treatment for testicular cancer, a student pilot decides to volunteer to transport pets needing rescue, shelter or adoption.

Forward Momentum, a coalition launched by a biopharmaceutical company and three partners, focuses on the health disparities faced by Black men with prostate cancer.

Published: September 29th 2020 | Updated:
Published: September 10th 2020 | Updated:

Published: September 29th 2020 | Updated:

Published: October 8th 2020 | Updated:

Published: October 13th 2020 | Updated:

Published: November 11th 2020 | Updated: